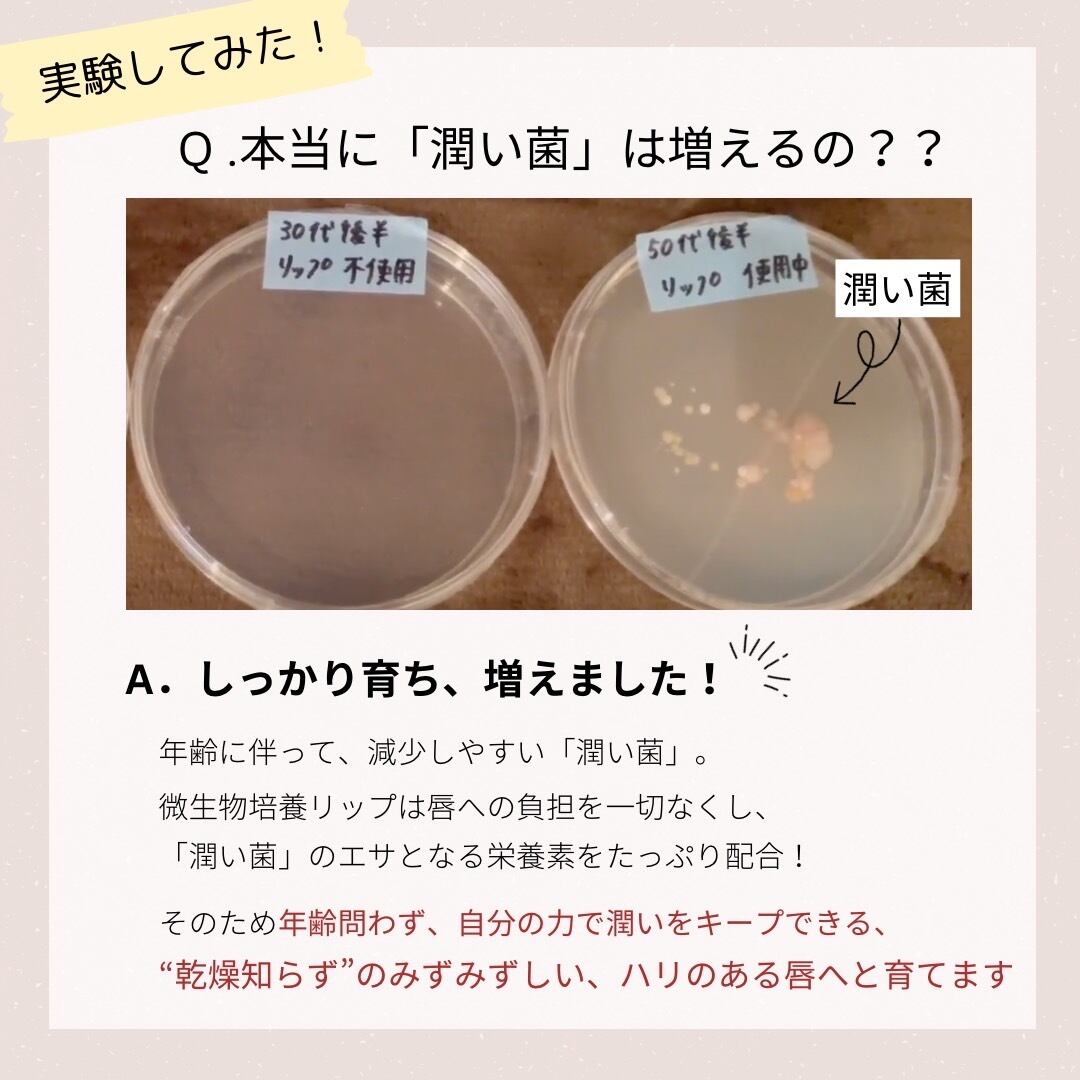

ジェニック(旧:ハイケア)-プロスキン 微生物培養リップクリーム(アトピーや超乾燥肌の方向け)
¥3,600
International shipping available
常に新しいモノづくりにチャレンジするジェニックジャパン(旧:ハイケアジャパン)が開発した世界で初めてのリップクリーム。
通常の、ワセリンで潤わせるリップではなく、唇の常在菌を元気にすることで自ら潤うリップクリームです。
もう荒れない唇へ。
唇を守る常在菌が劣勢になると理想的な保湿状態を保つことができません。
ジェニックは、常在菌の中でも特にプロピオン酸菌に注目。グリセリンや有機酸を生産するプロピオン酸菌が繁殖できる栄養成分を配合したリップクリームを開発しました。
ハイケア 微生物培養リップは、唇の皮膚環境に着目した天然油脂成分、有機酸塩成分、栄養成分を配合。冬の乾燥した季節でも唇にうるおいを与え、荒れを防ぎます。
目元や口元の乾燥にもお使い頂けます。
**************************
【製品名】ジェニック微生物培養リップ
【シリーズ】プロスキン 微生物育成シリーズ
【内容量】3ml (4〜6ヶ月分)
【製造販売元】株式会社FILTOM
***********************
【ご使用方法】
① 唇にこまめに塗布します
※ヘルペスなど唇に疾患がある方は、少量から塗布をしながら様子を見るようにしてください。
【成分一覧】
ホホバ油、ビーズワックス、白色ワセリン、シアバター、ブチレングリコール、プロピオン酸Na、カゼインペプトン、ガラクトオリゴ糖、酵母エキス、寒天、香料
<使用上のご注意>
※傷・湿疹等異常のある時は使わないでください。
※お肌に異常が生じていないかよく注意して 使用してください。
※お肌に合わないときは、ご使用をおやめください。
※赤み、かゆみ、刺激等の異常が あらわれた場合、専門医にご相談ください。
<保存方法>
※凍結、高温、直射日光を避けて、室温で保管してください。
※冷暗所保存。直射日光を避けて保存してください。車内など高い温度になる場所に保管しないでください。
-
レビュー
(4)